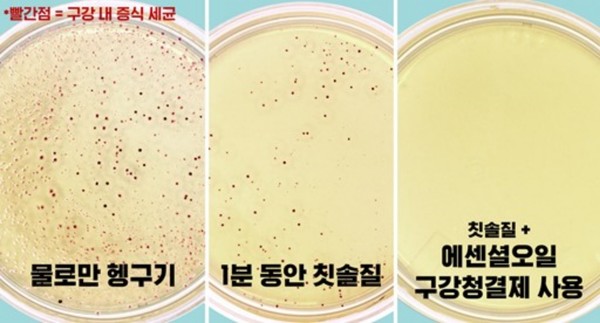

- 교정 환자 증가하지만 제대로 된 교정기 착용 후 구강관리법 인지 적어
- 구강청결제 병행으로 입 속 구석구석 헹궈내 치은염 및 치주질환 예방

[뉴스인] 김은영 기자 =코로나19 장기화로 마스크 착용이 일상화되어 치아교정을 하는 사람들이 증가하고 있다. 마스크를 착용하면 자연스럽게 입이 가려지기 때문에 그동안 교정 장치의 외형이 부담스러워 치료를 미뤄왔던 사람들이 교정치료를 시작하는 것이다.
일반적으로 교정장치를 착용하면 장치의 철사 사이사이를 꼼꼼히 칫솔질하는 것이 어려워 입 속 세균 제거에 어려움을 겪는 사람들이 많다. 교정 중 보철물 주변에 끼는 음식물들은 틈이 너무 작거나 구석진 곳에 있어서 칫솔질만으로는 제거하기 매우 힘들기 때문이다. 결국 음식물을 완전히 빼내지 못해 플라크가 형성되어 축적되고, 치석으로도 쉽게 변하게 된다. 실제로 미국 치과 교정학 저널(Angle Orthodontist)에 따르면 교정치료 6개월 뒤에는 38%, 12개월 뒤에는 46%가 크고 작은 충치나 잇몸질환을 나타낸다고 한다. 그래서 교정 중인 사람들은 플라크, 치석이 축적되어 구강질환으로 발전하지 않도록 구강 관리에 더 신경 쓸 필요가 있다.
교정 환자가 참고할 수 있는 구강관리법은 다음과 같다.
▲ 1. 거울 보면서 꼼꼼히 칫솔 및 치실질하기
음식섭취 이후 교정장치가 잘 닦이도록 디자인된 교정용 칫솔을 사용하여 꼼꼼히 칫솔 및 치실질을 해줘야 한다. 거울을 이용해서 교정 장치 주위, 치아 사이 및 교정장치 사이, 치아와 잇몸 사이 등 음식물이 끼기 쉬운 부분을 보면서 꼼꼼히 닦아야 한다.
▲ 2. 유해균 억제 효과 검증된 구강청결제 병행 사용하기
물리적인 방법인 칫솔 및 치실질을 하는 동시에 화학적인 방법이라 할 수 있는 구강청결제 사용을 병행하면, 액체라는 성분적 특성상 칫솔과 치실이 닿지 못하는 공간까지 효과적으로 관리할 수 있다.
구강내 모든 부분의 유해균을 관리하기 위해서 구강청결제를 사용해야 하는 이유는 구강청결제의 세정력에 있다. 칫솔질은 전체 구강 면적의 25% 이내밖에 관리하지 못하기 때문이다. 그러나 세균은 칫솔, 치실이 닿지 않는 치아 이외의 75% 공간에도 숨어있으며, 해당 부분까지 관리해야 치은염 및 치주질환 등을 예방할 수 있다.
또 실제로 칫솔질을 올바른 방법으로 충분한 시간 동안 하는 사람은 많지 않다. 사람들이 인지한 양치질 시간은 2.5분이나, 실제 양치질 시간은 1분 미만이었다는 연구 결과도 있다. 이에 대한 해결책으로 플라크와 치은염을 줄이기 위해 고안된 성분들이 다량 함유되어 있는 구강청결제를 사용해 입 속에 숨어있는 각종 유해균을 제거해 줄 수 있다.
구강청결제 제품 종류의 경우 주 성분인 에센셜오일 기반과 CPC(세틸피리디늄염화물수화물) 기반의 제품군으로 나뉘며 그에 따라 주요 효능이 다르다. 한 실험에서는 ▲에센셜오일 제품의 경우, 약 30%의 플라크 세포들이 죽거나 손상되었으며 이에 반해 CPC 기반 제품은 약 10%의 플라크 세포가 손상된 것으로 나타났다. 즉, 에센셜오일이 함유된 제품이 CPC 성분의 제품에 대비해 약 3배의 플라크 제거 효과를 보인 것이다. 이와 더불어 ▲‘치은염 감소 효과’ 관련 연구에서도 에센셜오일 성분이 65% 더 큰 효과를 보이는 것으로 보고됐다. ▲에센셜오일 성분 기반의 제품은 CPC 기반 제품에 비해 충치를 예방해 주는 불소 성분을 최대 7배 더 흡수해 충치 예방에도 더욱 효과적인 것으로 나타났다. 주성분 내용은 마트에 진열된 구강청결제 뒷면에서 쉽게 확인해볼 수 있다.

